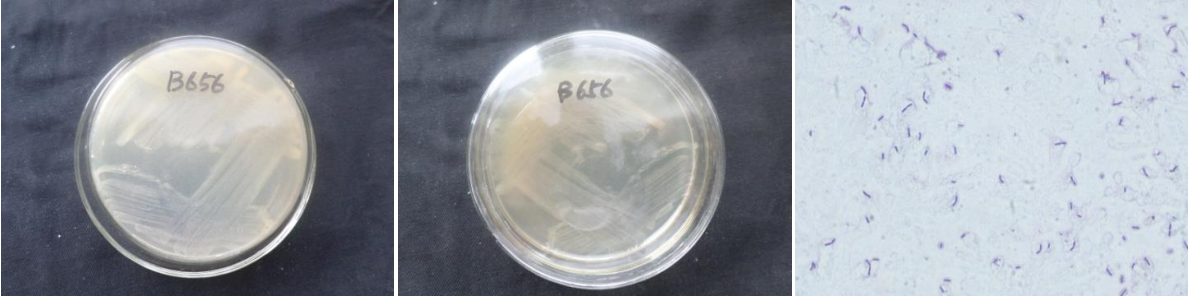

Loading...
| StrainNO | B656 |
| Classification | Bacillus |
| 16s rDNA sequence | AGGGGGCGGGCTGGCTCCAAAAGGTTACCTCACCGACTTCGGGTGTTACAAACTCTCGTGGTGTGACGGGCGGTGTGTACAAGG CCCGGGAACGTATTCACCGCGGCATGCTGATCCGCGATTACTAGCGATTCCAGCTTCACGCAGTCGAGTTGCAGACTGCGATCC GAACTGAGAACAGATTTGTGGGATTGGCTTAGCCTCGCGGCTTCGCTGCCCTTTGTTCTGCCCATTGTAGCACGTGTGTAGCCC AGGTCATAAGGGGCATGATGATTTGACGTCATCCCCACCTTCCTCCGGTTTGTCACCGGCAGTCACCTTAGAGTGCCCAACTGA ATGCTGGCAACTAAGATCAAGGGTTGCGCTCGTTGCGGGACTTAACCCAACATCTCACGACACGAGCTGACGACAACCATGCAC CACCTGTCACTCTGCCCCCGAAGGGGAAGCCCTATCTCTAGGGTTGTCAGAGGATGTCAAGACCTGGTAAGGTTCTTCGCGTTG CTTCGAATTAAACCACATGCTCCACCGCTTGTGCGGGCCCCCGTCAATTCCTTTGAGTTTCAGTCTTGCGACCGTACTCCCCAG GCGGAGTGCTTAATGCGTTTGCTGCAGCACTAAAGGGCGGAAACCCTCTAACACTTAGCACTCATCGTTTACGGCGTGGACTAC CAGGGTATCTAATCCTGTTCGCTCCCCACGCTTTCGCGCCTCAGCGTCAGTTACAGACCAGAGAGTCGCCTTCGCCACTGGTGT TCCTCCACATCTCTACGCATTTCACCGCTACACGTGGAATTCCACTCTCCTCTTCTGCACTCAAGTTCCCCAGTTTCCAATGAC CCTCCCCGGTTGAGCCGGGGGCTTTCACATCAGACTTAAGAAACC |
| Strain Morphology Photos | |
| Morphological Description | round;clam white;edge serrated;edge bumps;flat;multi-fold;slippy;sticky;waxy;Rod;having spore;bias in budding spores |